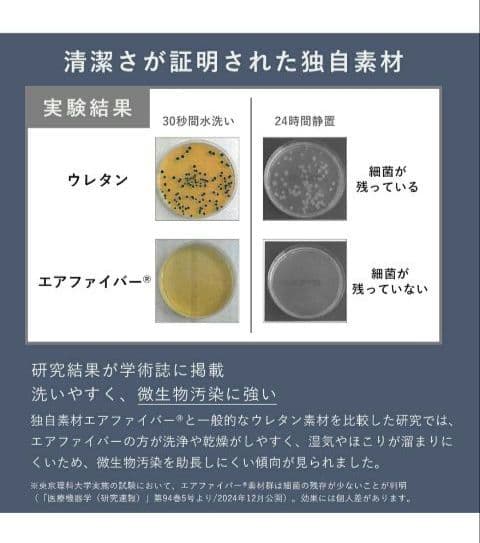
T*M様 【公式】エアウィーヴ シングル 折りたたみマットレス 三つ折り 厚さ8

マイストア
変更
お店で受け取る
(送料無料)
配送する
納期目安:
2026.03.13 18:54頃のお届け予定です。
決済方法が、クレジット、代金引換の場合に限ります。その他の決済方法の場合はこちらをご確認ください。
※土・日・祝日の注文の場合や在庫状況によって、商品のお届けにお時間をいただく場合がございます。
T*M様 【公式】エアウィーヴ シングル 折りたたみマットレス 三つ折り 厚さ8の詳細情報
エアウェーヴ公式サイトにて定価77000円で購入して、3年間使用しましたが、この度引っ越しで手放すこととなりました。※専門クリーニング店にて、クリーニングとローテーションをしましたので衛生的にご使用頂けます。ご安心くださいませ☆表面に少し毛羽立ちがございます。発送たのメル便にてお届けします。お部屋まで設置してもらえます。朝起きたらコンパクトに畳んで収納できる!一枚敷きが可能な三つ折りタイプのマットレス。厚さ9cmたっぷりのエアファイバー®が 肩・腰にやさしく、極上の寝心地を実現。フローリングや畳に敷いても寝心地が抜群に良く肩こりや腰痛の方へお勧めします。お手入れは縦置きにして通気させるだけ。カバーもマットレスの中も洗えて清潔です。【スペック】●シングル:幅約97cm×長さ約195cm×厚さ約9cm 重さ約9kg【素材】●カバー ・表面=ポリエステル55%:綿45% ・中綿=ポリエステル100% ・裏地=ポリエステル100% ・裏面=ポリエステル100%●中材(エアファイバー®) ・ポリエチレン100%【ご使用方法】畳やフローリング(床)に敷いて、一枚でお使いいただける三つ折りタイプのマットレスです。避難 災害 防災 観光地 買い物 スポーツ ジョギング ウォーキング 登山 介護 通学 通勤 メッシュ 撥水加工 晴雨 軽量 遠足 運動会 体育祭 お祭り 部活 旅行 夏休み 冬休み レジャー アウトドア キャンプ 海 川 釣り 船 ブラック 黒 普段使い 園芸 ガーデニング 植替え 剪定 雨 ウィンドブレーカー カッパ 傘 雪 観光 水仕事 エプロン ミシン 編み物 手仕事 DIY 日曜大工 汚れ防止 習い事 習字 掃除 年末 年始 子育て 公園 推し活 野外 ライブ ステージ オタ活 フェス 花火大会 まつり 祭り 縁日 絵画 絵具 油絵 スケッチ 写生 ストレッチ ヨガ ダイエット 着替 プール 秋祭り 紅葉 ブラックフライデー クリスマス 腰痛 肩こり コルセット ぎっくり腰 狭窄症 エアウェーブ 膝痛 サポーター 清潔 熟睡 爆睡 爆眠 軽い 高反発。エアーベッド Coleman コールマン ダブル キャップ 車中泊。ユ*カ様 nishikawa 【 西川 】マットレス シングル 三つ折り 厚さ9。西川エアーマットレスA.I.R.シングルサイズエアーマットレス。フランスベッド シングルサイズ 電動マットレス RP-3000。NIHON BED ダブルスプリングマットレス&dreambed ベッドフレーム。7999.テンピュール トッパーデラックス3.5 シングル。【中古】マニフレックス メッシュウイング セミシングル ミッドブルー。西川エアー メルセデスベンツ 限定品。VECELO マットレス シングル 極厚20cm 独立コイル 体圧分散 未開封。【美品!シモンズ セミダブルマットレス ビューティレストMaxima 引取歓迎】。【58n】アイリスオーヤマ エアリーマットレス HG90-S 茶①
ベストセラーランキングです
近くの売り場の商品
カスタマーレビュー
オススメ度 4.1点
現在、4441件のレビューが投稿されています。